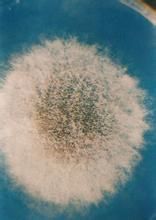
微小毛霉 微小毛霉

相關詞條
-
多變根毛霉
的根 毛霉均為微小根毛霉 [Rhizomucor pusillus...屬除微小根毛霉以外的另外一個種引起的人體毛霉 病, 很可能還是全世界第一...毛霉未見有接合孢子, 將我們保存的全部微小根毛霉 菌株與它分別配對時...
-
毛霉科
毛霉目中最大、最重要的 1科。孢囊梗自菌絲上發生,簡單不分枝至分枝多次,單生或成束。
-
多量毛霉
多量毛霉,是接合菌綱毛霉目中最大的一科。孢囊梗自菌絲上發生,簡單不分枝至分枝多次,單生或成束。在孢囊梗或其分枝的頂端形成孢子囊,全部為大型孢子囊,孢子囊...
多量毛霉 -
接合菌病
不佳。 (4)皮膚接合菌病 病原菌為微小根毛霉(最常見)。原發感染常由...壞死。臨床表現1.毛霉目感染臨床特點是很快出現發熱、組織壞死。不同的臨床...或其他部位毛霉的播散,開始皮損為痛或不痛紅斑、結節,逐漸擴大,以後中央出現...
病因 臨床表現 檢查 診斷 治療 -
現代醫學真菌檢驗手冊
犁頭霉6.4.2傘枝犁頭霉6.4.3透孢犁頭霉6.5根毛霉屬6.5.1米里根毛霉6.5.2微小根毛霉6.5.3多變根毛霉原變種6.5.4多變根毛霉...鑑定試驗6.1.3各論6.2毛霉目真菌6.2.1概論6.2.2各論6.3根...
內容介紹 作品目錄 -
真菌界
菌絲和菌絲體。菌絲體是常見的典型性營養體,由微小的絲狀物構成,它在基物上向...
主要特徵 真菌界信息 研究歷史 結構特徵 營養與生長 -
李鐵柱[建築師]
軟科學項目,2013-2014,主持4、乾酪加工專用微小毛霉凝乳酶...,張莉,楊貞耐. 重組微小毛霉凝乳酶的發酵條件及其酶學性質. 食品科學...,李倬林,楊貞耐. 重組微小毛霉凝乳酶的分離與純化. 中國釀造,2010...
簡介 從業經歷 代表作品 同名博士 主要研究方向 -
真菌
細胞核,如低等真菌中的根霉、毛霉、水霉等的菌絲。另一類是有隔菌絲,即菌絲...
定義 兩大結構 繁殖方式 起源和演化 系統分類